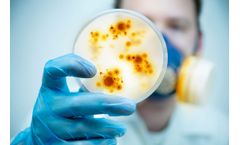
Lubron - Granular Activated Carbon Filtration

- Home
- Equipment
Refine by
Lubron Environmental Equipment & Supplies
10 equipment items found
Manufactured by:Lubron UK Limited based inColchester, UNITED KINGDOM
Bimatic water softeners are a range of high quality industrial units that utilise a brass multiport control valve to efficiently produce soft water for any industrial or process application. The integrated water meter and regeneration controller ensures the availability of softened water at all times due to the duty/standby mode of operation. Bimatic water softeners are , durable and require low ...
Manufactured by:Lubron UK Limited based inColchester, UNITED KINGDOM
Lubron have been producing water softeners since 1978, with constant improvements to the range. A new addition to the range is the PROLINE SXT. Development, design and construction of water softeners is undertaken totally inhouse in line with current European directives. Lubron is one of the leading water treatment providers in the Netherlands and is based in Oosterhout, Netherlands with ...
Manufactured by:Lubron UK Limited based inColchester, UNITED KINGDOM
Water in underground springs and boreholes can dissolve Iron and Manganese from the surrounding rocks. The water under ground is devoid of Oxygen, and the Iron and Manganese are soluble in water because of this. However, when the water is pumped to the surface and exposed to the Oxygen in the air, the Iron and Manganese become insoluble. This cause them to precipitate out of the water, leaving ...
Manufactured by:Lubron UK Limited based inColchester, UNITED KINGDOM
JR and Twin water softeners are a range of high quality industrial units that utilise a brass multiport control valve to efficiently produce soft water for any industrial or process application. On the JR and Twin units the integrated water meter and regeneration controller ensures the availability of softened water at all times due to the optional duty/standby mode of operation. JR and Twin ...
Manufactured by:Lubron UK Limited based inColchester, UNITED KINGDOM
Senior High Flow automatic water softeners are a range of quality engineered units designed for the efficient production of soft water for all industrial and commercial requirements. The control versatility and wide range of options ensures that these systems can be configured specifically for customer requirements and fully integrate with all on-site equipment. Selection of durable and proven ...
Manufactured by:Lubron UK Limited based inColchester, UNITED KINGDOM
Tap water is used in every home and business for many purposes where the removal of unwanted substances from the tap water is often desirable. To prevent the most common problems due to the presence of hardness of the water, softening by means of the principle of ion exchange remains the most reliable solution. The benefits of softened water are numerous, such as extended life time of boilers, no ...
Manufactured by:Lubron UK Limited based inColchester, UNITED KINGDOM
The OSMOSTAR S is a new series of durable reverse osmosis installations with capacities of up to 2200 litres of desalinated water per hour. Larger capacities on request. The frame of the new OSMOSTAR S is made from stainless steel and is very compact. The systems are provided with reliable microprocessor controls and conductivity monitoring as the ...
Manufactured by:Lubron UK Limited based inColchester, UNITED KINGDOM
Our soil contains many minerals and pollutants that can disrupt processes and impact the quality of your products. Borehole water can normally be used effectively if substances such as sodium and chloride are reduced. Reverse Osmosis is the most suitable technique for achieving this and the Lubron HORTI PURE RO series is the ideal equipment to ...
Manufactured by:Lubron UK Limited based inColchester, UNITED KINGDOM
Lubron has developed the LK 120 especially for the hotel and catering industry. This reverse osmosis installation is the smallest in our range. This extremely compact installation has been specially developed to supply a glass washer with completely pure water during the rinse cycle. This results in exceptional water quality. The quality is so good, that it gives a spotless result on glassware ...
Manufactured by:Lubron UK Limited based inColchester, UNITED KINGDOM
Activated Carbon is effective for the removal of Chlorine and Organics which can damage and foul Ion Exchange resin and Reverse Osmosis membranes. Activated Carbon has the highest volume of adsorbing porosity, of any material known to mankind. It can be made from a number of substances containing a high carbon content such as coal, coconut shells and wood. Carbon filter systems come ...